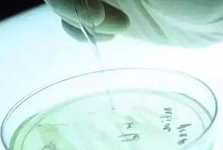

永康古丽中西医结合医院
永康古丽中西医结合医院科室建制齐全,重点建设科室有:急诊科、内科、外科、妇产科、妇科专业、医学检验科、医学影像科、X线诊断专业、超声诊断专业、心电诊断专业、脑电及脑血流图诊断专业、中医科、中西医结合科等....
作为一个致力于为人类健康服务的医疗机构,永康古丽中西医结合医院认为医学从业者必须具备高尚的医德和精湛的医术。永康古丽中西医结合医院要求每一位医疗人员要像对待自己的家人一样对待每一位患者,时刻以患者的切身利益为先....

妇科、男科一站式检查
仅需5.1元,一年仅此一次
仅需5.1元,一年仅此一次
人流手术
(术前检查+术中处置+术后康复)只需560元
(术前检查+术中处置+术后康复)只需560元
| 术前检查 | 术中处置 | 术后康复 |
| 血糖、血常规、尿常规、白带常规、凝血、心电图、B超检查、肝功能 | 手术费、术中药费、材料费、心电监护 | 床位费、观察费、护理费、术后B超免费复查一次 |
| 在线预约咨询优惠价:560元 | ||
妇科、男科、外科手术
最高优惠510元
最高优惠510元

 妇科内诊
妇科内诊
 血常规
血常规
 尿常规
尿常规
 白带常规
白带常规
 BV检测
BV检测
 阴道镜检查
阴道镜检查
 肝功能
肝功能
 肾功能
肾功能
 胸透
胸透
 心电图
心电图
 彩超
彩超
 血常规
血常规
 尿常规
尿常规
 前列腺指检
前列腺指检
 性功能检测
性功能检测
前列腺液常规
前列腺液常规
 肝功能
肝功能
 肾功能
肾功能
 胸透
胸透
 心电图
心电图
 彩超
彩超



